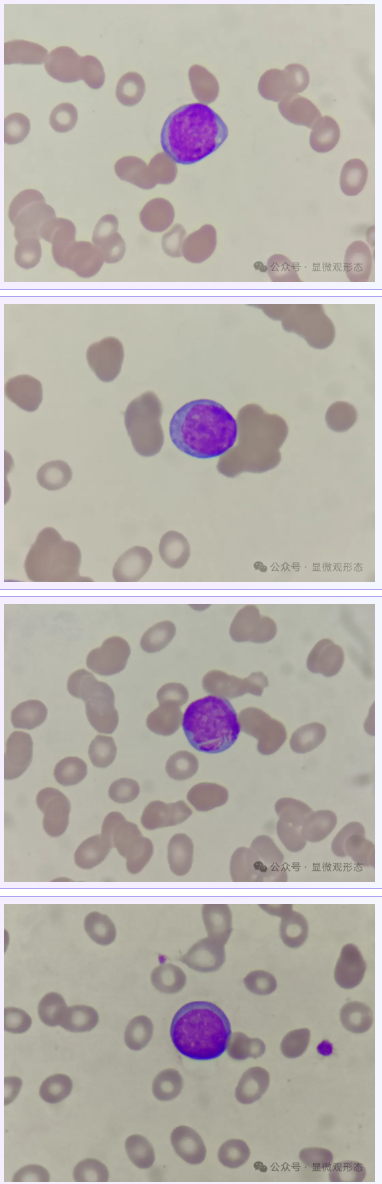

血常规复检要重视,这个教训太深刻了
作者 | 余启泓
单位 | 信阳市中心医院
01病例起源患者,女,40+岁,慢性胃炎患者,检查血细胞分析,结果如下:

仪器报警信息如下:

仪器有核左移?白细胞减少、贫血、血小板减少等报警。散点图看不出太大的问题,因为是慢性胃炎患者,大细胞性贫血,小编建议先完善叶酸、维生素B12检查,先排除巨幼细胞性贫血。
02形态特征
外周血涂片,以下所有图片瑞吉染色,在油镜(1000倍)下,手机放大约3.5倍拍摄。
外周血细胞形态:中性杆状核粒细胞占7%,中性分叶核粒细胞占34%,淋巴细胞占51%,单核细胞占7%,原始细胞占1%,偶找到有核红细胞。
03简要病史
现病史:10余年前因晕倒在其他省卫生院检查血常规提示贫血,给予输液治疗,头晕好转,3天前因胸口痛在我院消化内科检查血常规提示三系减少(小编注:01部分的血常规),皮肤粘膜无出血点,今为求进一步诊治来院。
既往史:否认高血压、糖尿病、冠心病等病史。
体格检查:体温:36.5℃,脉搏:112次/分,呼吸:22次/分,血压:102/66mmHg。中重度贫血貌。

04同事交流外周血中,同事发现可疑细胞,遂来微信交流沟通(那天小编下夜班)

上图这个细胞很像原始细胞,非常可疑。

找到两个就更有自信了。

最终,小编建议和临床沟通,有血液病可能,建议完善骨髓穿刺等检查。
05个人体会
该患者血常规示白细胞减少,重度贫血(大细胞性贫血),血小板减少,镜检可见原始细胞约占1%(叶酸和维生素B12正常),提示临床医生,检验考虑血液系统疾病,建议完善相关检查。
给我们敬业的同事点赞,虽然早已到下班时间(12点),但是并未到点就下班,而是继续在实验室寻找有力的检验依据,这种精神需要形者具备,如果坐不到椅子上,学好形态是不太容易的。
临床也建议患者住院进一步完善检查,然而,患者及家属拒绝住院。

半个月后,患者出现了呼吸困难症状,她拨打朋友电话,并在朋友的陪同下再次来院,期间出现呼吸心跳骤停,大动脉搏动消失等症状,经急诊科积极抢救后,患者心跳恢复。遗憾的是,虽在重症医学科经过积极治疗,患者最后神志还是处于昏迷状态,家属商议后要求放弃治疗,自动出院。
虽然到最后这一步,中间有诸多关键因素,然而半个月前如果住院积极治疗,是不是可以避免这样的悲剧(十年期间一直贫血?中间有无具体查找原因并经过规范化治疗?)。40+岁还很年轻,生命只有一次,人生没有如果。希望所分享的此文让更多非医学专业人士看到并有所启发,珍爱生命!
内容来源 | 显微观形态
图片来源 | veer、ibaotu
排版 | znm
审校 | 金宝

